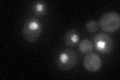
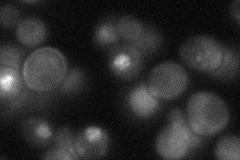
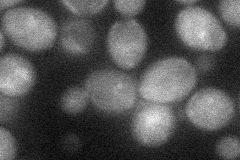
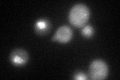
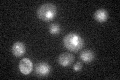

View description
Essential helicase component of heterohexameric MCM2-7 complexes which bind pre-replication complexes on DNA and melt the DNA prior to replication; accumulates in the nucleus in G1; homolog of S. pombe Cdc21p
Localization:
Intensity:
Fold change:
Significance:
-
C’ GFP library in SD
nucleus:cytosol40.87 -
N' NOP1pr-GFP in SD

cytosol,nucleus77.9136 -
N' TEF2pr-mCherry in SD

cytosol31.3478 -
N' NATIVEpr-GFP in SD
punctate,nucleus35.0708 -
N' TEF2pr-VC and Cyto-VN in SD
cytosol40.7992 -
C’ GFP library in SD+DTT
nucleus.cytosol42.611.04No -
C’ GFP library in SD+H2O2

nucleus.cytosol43.091.05No -
C’ GFP library in Starvation Media
nucleus,cytosol34.330.83No -
C’ GFP library on the background of Pup2-DaMP

nucleus:cytosol -
C’ GFP library on the background of CCT mutant

nucleus:cytosol48.18641.17856No
